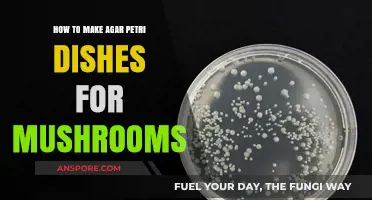
Mastering Mushroom Cultivation: A Step-by-Step Guide to Agar Petri Dishes

Making agar gel for mushroom culture is a fundamental step in cultivating mushrooms, as it provides a sterile, nutrient-rich medium for mycelium growth. To prepare agar gel, you’ll need a few key ingredients: agar powder, water, and a nutrient source such as light malt extract or sugar. Begin by sterilizing all equipment to prevent contamination. Mix the agar powder and nutrient source with water, then heat the solution until it boils, ensuring the agar fully dissolves. Once prepared, pour the hot mixture into sterile containers, such as Petri dishes or jars, and allow it to cool and solidify. The resulting agar gel serves as a stable substrate for inoculating mushroom spores or mycelium, enabling controlled and contamination-free growth in a laboratory or home cultivation setting.
| Characteristics | Values |
|---|---|
| Agar Type | Laboratory-grade agar (e.g., bacteriological agar, agar-agar powder) |
| Concentration | 1.5-2.0% (15-20 grams per liter of water) |
| Water | Distilled or deionized water (to avoid contaminants) |
| Sterilization Method | Autoclaving at 121°C (250°F) for 15-30 minutes |
| pH Level | 5.6-6.0 (slightly acidic, adjusted with buffer solutions if needed) |
| Nutrient Additives | Malt extract (10-20 grams per liter), dextrose (20 grams per liter), or other carbon sources |
| Container | Sterile Petri dishes or glass jars with lids |
| Cooling Time | 30-60 minutes in a laminar flow hood or clean environment |
| Storage | Refrigerated at 4°C (39°F) for up to 6 months |
| Contamination Prevention | Work in a sterile environment, use sterile techniques, and flame instruments |
| Common Uses | Mushroom tissue culture, spore germination, mycelium growth |
| Alternative Recipes | Potato dextrose agar (PDA), MYA (malt extract agar with antibiotics) |
| Cost | $0.50-$2.00 per liter (depending on agar and additives) |
| Shelf Life (Prepared Agar) | 1-2 months when stored properly |
| Key Tip | Always sterilize equipment and work in a clean environment to prevent contamination |
Explore related products
$7.99 $8.38
What You'll Learn
- Sterilize agar powder and water mixture in a pressure cooker for 30 minutes
- Add nutrients like sugar, vitamins, or minerals to support mushroom mycelium growth
- Pour sterilized agar into jars or petri dishes, ensuring no contamination
- Cool agar gel at room temperature until it solidifies completely before inoculation
- Maintain sterile conditions using a still air box or laminar flow hood

Sterilize agar powder and water mixture in a pressure cooker for 30 minutes
To sterilize the agar powder and water mixture in a pressure cooker for 30 minutes, begin by preparing your agar solution. Measure the required amount of agar powder and distilled water according to your recipe, typically around 20-25 grams of agar per liter of water. Mix the agar powder thoroughly into the water in a heat-resistant container, ensuring there are no lumps. Stir the mixture until the agar is fully dissolved, and then allow it to sit for a few minutes to hydrate properly. This step is crucial for achieving a consistent gel texture later on.
Once your agar solution is ready, transfer it into sterilization-safe containers, such as mason jars or glass bottles with loose-fitting lids. It’s important not to tighten the lids completely, as this allows steam to escape during the sterilization process. Fill the containers no more than three-quarters full to prevent overflow when the mixture expands under pressure. Label the containers with the date and contents for future reference, as this will help you keep track of your prepared agar solutions.
Next, prepare your pressure cooker by adding enough water to the bottom to create steam but not so much that it touches the containers holding the agar solution. Place the filled containers on the rack inside the pressure cooker, ensuring they are stable and not overcrowded. Secure the lid of the pressure cooker according to the manufacturer’s instructions, making sure the vent is closed for proper sterilization. Turn on the heat to high and allow the pressure cooker to reach full pressure, which is typically indicated by a steady stream of steam or the rising of the pressure regulator.
Once the pressure cooker has reached full pressure, start timing the sterilization process for 30 minutes. Maintain a consistent heat level to keep the pressure stable throughout this period. Sterilization at high pressure and temperature is essential to eliminate any contaminants that could compromise your mushroom culture. After 30 minutes, turn off the heat and allow the pressure cooker to depressurize naturally. Do not attempt to release the pressure manually, as this can be dangerous and may affect the sterilization process.
Finally, once the pressure cooker has fully depressurized and returned to room pressure, carefully open the lid and remove the containers of sterilized agar solution. Allow them to cool to room temperature before tightening the lids completely. The sterilized agar solution can now be stored in a cool, dark place until you are ready to use it for mushroom culture. Proper sterilization ensures a clean and contaminant-free environment for your mushroom mycelium to grow, increasing the chances of a successful culture.
Do Alice Mushrooms Induce Psychedelic Trips? Exploring Their Effects
You may want to see also

Add nutrients like sugar, vitamins, or minerals to support mushroom mycelium growth
When preparing agar gel for mushroom culture, adding nutrients like sugar, vitamins, or minerals is crucial to support the vigorous growth of mushroom mycelium. Sugar, particularly in the form of dextrose or sucrose, serves as the primary energy source for the mycelium. To incorporate sugar, dissolve 10-20 grams of dextrose or sucrose into 1 liter of water before adding the agar. This concentration provides sufficient carbohydrates without creating an overly osmotic environment that could stress the mycelium. Stir the mixture thoroughly to ensure the sugar is fully dissolved before heating and sterilizing the solution.
Vitamins play a vital role in enhancing mycelium metabolism and overall health. Common vitamins to add include thiamine (vitamin B1) and riboflavin (vitamin B2), which are essential for enzyme function and energy production. Add 0.1-0.5 grams of a vitamin supplement or a specific vitamin mix to the agar solution. These vitamins should be mixed into the liquid before sterilization to ensure even distribution. Be cautious not to overuse vitamins, as excessive amounts can inhibit growth rather than promote it.
Minerals are equally important, providing essential elements like nitrogen, phosphorus, and potassium that mycelium requires for structural and metabolic processes. Common mineral sources include powdered gypsum, calcium carbonate, or specialized mineral mixes designed for mushroom cultivation. Add 1-2 grams of a mineral supplement per liter of agar solution. These minerals should be finely ground and thoroughly mixed to avoid clumping. Sterilize the solution to eliminate contaminants while ensuring the minerals remain bioavailable for the mycelium.
Another effective nutrient addition is yeast extract, which provides a broad spectrum of vitamins, minerals, and amino acids. Incorporate 1-3 grams of yeast extract per liter of agar solution to create a nutrient-rich environment. Yeast extract is particularly beneficial for species that require complex nutrients for optimal growth. Mix it into the liquid before sterilization, ensuring it dissolves completely. This addition can significantly enhance mycelium colonization speed and density.
Finally, consider adding organic nutrients like corn syrup or malt extract for species that thrive on diverse carbohydrate sources. Add 10-20 milliliters of these liquids per liter of agar solution, adjusting based on the specific needs of the mushroom species. These organic supplements provide additional sugars and trace nutrients that can improve mycelium vitality. Always sterilize the final agar mixture to prevent contamination, ensuring the added nutrients remain sterile and effective for supporting robust mycelium growth.
Easy Homemade Cream of Mushroom Soup Recipe: A Comforting Classic
You may want to see also

Pour sterilized agar into jars or petri dishes, ensuring no contamination
Once your agar mixture has been sterilized in the pressure cooker and allowed to cool slightly, it’s time to pour it into jars or petri dishes while ensuring no contamination. Work in a clean, sterile environment, preferably near a still air box or laminar flow hood if available. If you don’t have these tools, choose a room with minimal airflow and wipe down surfaces with 70% isopropyl alcohol to reduce airborne contaminants. Ensure your hands are clean and consider wearing gloves to minimize the introduction of bacteria or fungi from your skin.
Prepare your jars or petri dishes by placing them on a clean, disinfected surface. If using jars, remove the lids and set them aside, ensuring they remain sterile by keeping them upside down or covered until needed. For petri dishes, have them ready with the lids slightly open for quick access. The agar should be at a temperature where it is still liquid but not so hot that it risks melting plastic containers or causing burns—typically around 50-60°C (122-140°F). Use a sterile spoon or spatula to gently stir the agar in the flask or container to ensure any settled nutrients are evenly distributed.
Pour the sterilized agar into the jars or petri dishes in a smooth, controlled manner to avoid splashing or introducing contaminants. For jars, fill them about 2-3 cm from the top, leaving enough space to seal them properly. Tilt the jar slightly and pour the agar against the side to minimize bubble formation. For petri dishes, pour quickly but carefully to create a thin, even layer of agar, then immediately close the lid to prevent contamination. Work swiftly but deliberately, as the agar will begin to solidify as it cools.
After pouring, allow the agar to cool and solidify at room temperature. Avoid moving or disturbing the jars or petri dishes during this time to ensure the agar sets evenly. Once solidified, inspect the containers for any signs of contamination, such as discoloration or unusual spots. Properly label each jar or dish with the date and type of agar used for future reference. Store them in a cool, dark place until you’re ready to inoculate with mushroom mycelium.
To further ensure no contamination, consider flame sterilizing the lip of the flask or container before pouring the agar. Use a bunsen burner or alcohol lamp to pass the flame quickly over the opening to kill any surface contaminants. Similarly, if using jars, flame sterilize the mouth of the jar and the underside of the lid before sealing. This extra step significantly reduces the risk of airborne contaminants entering the agar during the pouring process. Always prioritize sterility at every stage to increase the success rate of your mushroom culture.
Unlocking Special Mushrooms in Super Mario Maker: A Step-by-Step Guide
You may want to see also
Explore related products

Cool agar gel at room temperature until it solidifies completely before inoculation
After preparing your agar gel mixture for mushroom culture, it’s crucial to handle the cooling process with care to ensure the agar solidifies properly before inoculation. Once the agar solution has been sterilized in an autoclave or pressure cooker and poured into sterile containers, the first step is to allow it to cool at room temperature. Avoid the temptation to speed up the process by placing the containers in a refrigerator or using a fan, as rapid cooling can introduce contaminants or cause uneven solidification. Room temperature cooling ensures a consistent and stable gel formation, which is essential for successful mushroom cultivation.
During the cooling process, place the containers on a clean, flat surface away from direct sunlight, drafts, or areas prone to dust. Cover the containers loosely with aluminum foil or a lid to prevent airborne contaminants from settling on the surface of the agar while still allowing air circulation. The cooling time typically ranges from 1 to 2 hours, depending on the volume of agar and the ambient temperature. It’s important to monitor the agar during this period to ensure it solidifies evenly without cracking or separating from the container walls.
As the agar cools, it will transition from a liquid to a semi-solid state and eventually become a firm, jelly-like gel. To confirm that the agar has solidified completely, gently tilt the container. If the agar moves slightly but maintains its shape and doesn’t slosh like a liquid, it is ready for inoculation. Incomplete solidification can lead to contamination or difficulty in transferring mycelium, so patience is key during this stage.
Once the agar gel has fully solidified, it should be inspected for any signs of contamination, such as discoloration or unusual odors. If the agar appears clear and free of impurities, it is safe to proceed with inoculation. However, if any issues are detected, discard the agar and sterilize the containers again before starting the process over. Properly solidified agar provides a stable, nutrient-rich substrate for mycelium growth, making this step a critical foundation for successful mushroom cultivation.
Finally, after confirming the agar has solidified completely, it’s essential to maintain sterility during the inoculation process. Work in a clean environment, such as a still air box or laminar flow hood, and use sterile tools to transfer the mushroom culture to the agar. Cooling the agar gel at room temperature until it solidifies completely ensures the integrity of the substrate, setting the stage for healthy mycelium colonization and a thriving mushroom culture.
Mastering the Perfect Cheese and Mushroom Omelette: Easy Steps
You may want to see also

Maintain sterile conditions using a still air box or laminar flow hood
Maintaining sterile conditions is crucial when preparing agar gel for mushroom culture, as contamination can ruin your entire project. One of the most effective ways to achieve this is by using a still air box or a laminar flow hood. These tools create a controlled environment that minimizes the introduction of airborne contaminants, ensuring your agar remains sterile throughout the process. A still air box is a simple, enclosed workspace that limits the entry of external particles, while a laminar flow hood provides a continuous stream of filtered air, actively pushing contaminants away from your work area.
To begin, set up your still air box or laminar flow hood in a clean, clutter-free area. If using a still air box, ensure it is properly sealed and equipped with gloves or arm holes to manipulate items inside without exposing the interior to the external environment. For a laminar flow hood, turn it on at least 15–20 minutes before starting to allow the air to fully filter and create a sterile field. Clean all surfaces inside the box or hood with 70% isopropyl alcohol or another suitable disinfectant, paying special attention to areas where you will place your materials and tools.
Once your workspace is prepared, organize all necessary materials—such as agar, Petri dishes, and inoculation tools—within the still air box or under the laminar flow hood. Ensure all items are sterilized before introducing them into the sterile environment. Use a flame from an alcohol burner or a sterilized lighter to create a sterile field around your work area, especially when opening Petri dishes or transferring agar. This practice helps to kill any airborne contaminants that might settle on your materials.
When working inside the still air box or laminar flow hood, move slowly and deliberately to avoid disturbing the sterile environment. Keep your arms and tools within the workspace at all times, and minimize unnecessary movements that could introduce contaminants. If using a laminar flow hood, always work with the airflow directed toward your materials, as this pushes particles away from your agar and culture dishes. For a still air box, maintain a calm, controlled atmosphere to prevent dust or particles from settling on your work.
Finally, after completing your agar preparation, carefully seal all Petri dishes or culture containers to prevent contamination. Turn off the laminar flow hood or close the still air box, ensuring it remains clean for future use. Properly dispose of any waste materials and sterilize your tools again before storing them. By following these steps and maintaining strict sterile conditions with a still air box or laminar flow hood, you significantly increase the chances of successfully preparing uncontaminated agar gel for mushroom culture.
Do Tree House Magic Mushroom Gummies Induce Psychedelic Trips?
You may want to see also
Frequently asked questions
The basic recipe includes 20-25 grams of agar powder, 1 liter of distilled water, and 20-40 grams of dextrose (sugar). Mix the ingredients, boil until dissolved, sterilize, and pour into sterile containers.
It’s not recommended. Tap water may contain contaminants or minerals that can interfere with mushroom growth. Distilled or purified water ensures a sterile environment.
After preparing the agar mixture, pour it into sterile containers (such as Petri dishes or jars) and pressure cook at 15 PSI for 45-60 minutes to ensure sterilization.
Properly sterilized and sealed agar gel can last several months when stored in a cool, dark place. However, it’s best to use it within 1-2 months for optimal results.